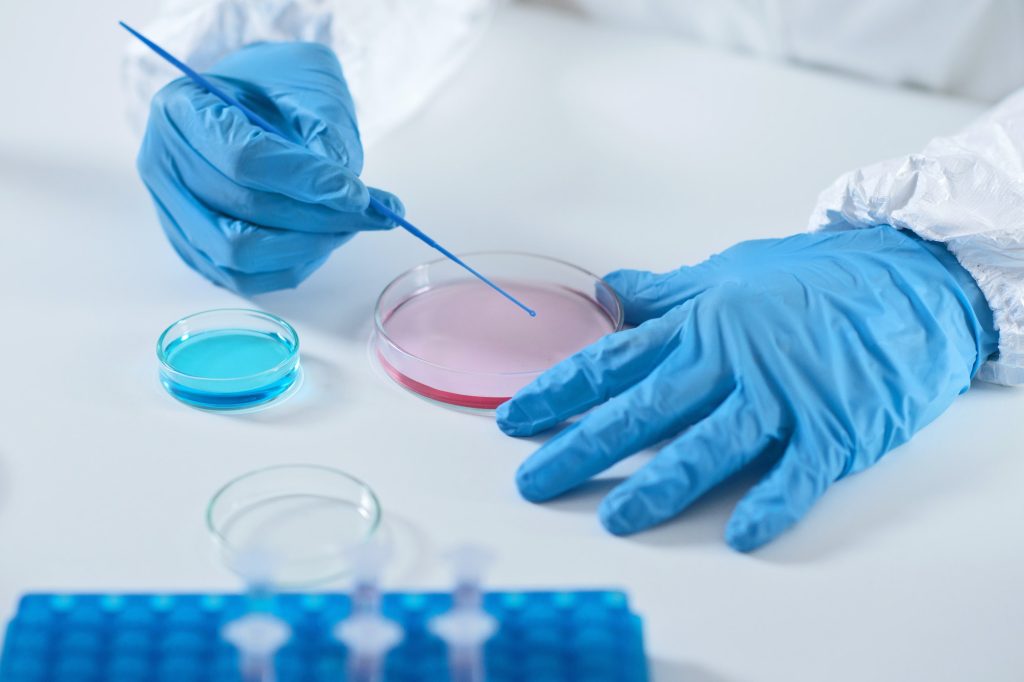

Labkesda Depok
Mini but Meaningful
“Laboratorium Kesehatan Terbaik di Kota Depok Menuju Depok Maju, Berbudaya dan Sejahtera Tahun 2026”
Layanan
Pemeriksaan Layanan Instalasi Patologi Klinik dan Immunologi, Instalasi Biomolekuler dan Mikrobiologi dan Instalasi Kesehatan Lingkungan, Vektor, dan Binatang Pembawa Penyakit
- Hematologi
- Kimia Darah
- Imunoserologi
- Urinalisa
- Faeces
- RT PCR Covid-19
- TCM TB
- Mikrobiologi
- Pengujian Air Bersih
- Pengujian Air Minum
- Pengujian Makanan
- dll

Kabar Terbaru
Berita, Kegiatan, dan Promosi
UPTD LABKESDA DEPOK BUKA LAYANAN PEMERIKSAAN KESEHATAN LINGKUNGAN
Depok, 21 Mei 2024 – Wali Kota Depok meresmikan layanan pemeriksaan baru UPTD Labkesda Kota Depok yang bernama Laboratorium Kesehatan Lingkungan. Kini, masyarakat Kota Depok dapat dengan mudah melakukan pemeriksaan…
WASPADA! CACAR MONYET (MONKEYPOX) MENGINTAI!
Kementrian Kesehatan RI (Kemenkes) telah mengkonfirmasi adanya kasus positif cacar monyet atau sering disebut Monkeypox atau Mpox di Indonesia. Mari kita waspadai! Apa itu Cacar Monyet (Monkeypox) ? Penyakit akibat…
IMUNISASI ROTAVIRUS, MENCEGAH DIARE PADA BAYI
Apakah Bayi kamu sudah diberi Imunisasi Rotavirus? Kalau belum, ayo disegerakan! Pastikan Bayi Anda mendapat Imunisasi Rotavirus (RV) 3 dosis tepat waktu, yaitu ketika Bayi berada di usia 2, 3…
CORE VALUE
CALM
Competent, Actual, Learning, & Mindful
Competent
Selalu berupaya untuk menjadi laboratorium kesehatan yang ahli dibidangnya. Selalu bekerja dengan penuh tanggung jawab. Selalu berupaya mewujudkan SDM yang kompeten
Actual
Selalu mengikuti perkembangan terkini, baik teknologi, situasi, dan lain-lain
Learning
Selalu bersemangat belajar hal baik
Mindful
Selalu berhati-hati dan penuh kesadaran dalam bekerja
Punya pertanyaan untuk kami ?
Pertanyaan Populer
Frequently Ask Questions
Pengunjung kami biasanya menanyakan ini
Anda dapat menghubungi Labkesda Depok ke (021) 22920279, 081386996920 dan dapat menghubungi sosial media Labkesda Depok di Facebook & Instagram labkesdadepok atau email ke suaralabkesdakotadepok@gmail.com
Waktu layanan: Senin s/d Jum'at | Pukul 08:00-12:00
Ketika Anda tiba di Labkesda Depok, segera lakukan skrinning di pintu masuk Gedung Labkesda Depok dengan scan barcode Peduli Lindungi dan pengecekan suhu tubuh diarahkan oleh Petugas Keamanan. Jika skrinning Anda aman, ambil nomor antrian dimeja petugas keamanan. Staf pendaftaran akan memanggil berdasarkan nomor urut antrian pendaftaran. Anda diharapkan menunjukkan kartu identitas dan/atau kartu pemeriksaan. Kemudian, staf pendaftaran akan mendaftarkan Anda sesuai dengan keperluan kunjungan. Pastikan bahwa data yang dikonfirmasi oleh petugas pendaftaran sudah sesuai dengan pelayanan yang Anda butuhkan. Seluruh informasi yang Anda berikan disimpan dalam sistem informasi Labkesda Depok dan bersifat rahasia.
Anda dapat mendaftar melalui Puskesmas di wilayah Kota Depok dan/atau Rumah Sakit di wilayah Kota Depok
Labkesda Depok menerima rujukan pemeriksaan TB. Anda dapat mendaftar melalui Puskesmas di wilayah Kota Depok dan/atau Rumah Sakit di wilayah Kota Depok
Anda dapat melampirkan KTP/KK/PASSPORT
Anda hanya perlu melampirkan kartu pemeriksaan
Kami tidak memiliki wewenang untuk mengeluarkan Surat Keterangan Bebas Narkoba (SKBN). Kami hanya mengeluarkan hasil pemeriksaan dari tes Narkoba